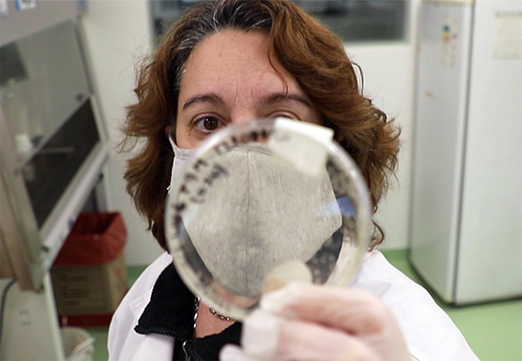

Menu Principal:
Investigadores argentinos logran neutralizar el SARS-CoV-2 con anticuerpos derivados de llamas y huevos
La capacidad de estas moléculas de inhibir la infección viral provocada por el patógeno que causa la COVID-19 fue puesta a prueba en ensayos tanto con pseudovirus como con el virus salvaje.
 En sólo siete meses, un equipo de investigadores del CONICET y del Instituto Nacional de Tecnología Agropercuaria (INTA) obtuvo nanoanticuerpos monoclonales recombinantes VHH provenientes de llamas, y anticuerpos policlonales IgY derivados de la yema de los huevos de gallina, capaces de neutralizar la infección por el coronavirus SARS-CoV-2. Estos resultados posicionan a la Argentina como el primer país de Sudamérica con la potencialidad de convertir estas moléculas en productos terapéuticos.
En sólo siete meses, un equipo de investigadores del CONICET y del Instituto Nacional de Tecnología Agropercuaria (INTA) obtuvo nanoanticuerpos monoclonales recombinantes VHH provenientes de llamas, y anticuerpos policlonales IgY derivados de la yema de los huevos de gallina, capaces de neutralizar la infección por el coronavirus SARS-CoV-2. Estos resultados posicionan a la Argentina como el primer país de Sudamérica con la potencialidad de convertir estas moléculas en productos terapéuticos.Los ensayos de neutralización llevados a cabo tanto con pseudovirus como con el virus salvaje confirmaron que estas moléculas inhiben la infección viral provocada por el SARS-CoV-2, resultando tratamientos innovadores contra la enfermedad de COVID-19 y complementarios a las vacunas y otros métodos disponibles.
Roberto Salvarezza, Ministro de Ciencia, Tecnología e Innovación de la Nación, se refirió al logro de los anticuerpos monoclonales de llama y a los policlonales de yema, y los consideró “dos posibilidades de terapia que se suman a otras que han desarrollado científicos y científicas, investigadores e investigadoras que, nuevamente, muestran las capacidades de nuestros investigadores de trabajar y lograr, en tiempos récord, productos de innovación”.
 En esta línea, agregó: “Es una muestra de la capacidad que tiene nuestro país y de nuestros investigadores. En esta pandemia estamos viendo el camino, el de búsqueda de que nuestro conocimiento llegue a la sociedad a fin de solucionar los problemas. Me siento orgulloso y destaco todo el mérito del grupo que estuvo trabajando . Un gran éxito y esperemos que se cumplan las etapas que faltan”..
En esta línea, agregó: “Es una muestra de la capacidad que tiene nuestro país y de nuestros investigadores. En esta pandemia estamos viendo el camino, el de búsqueda de que nuestro conocimiento llegue a la sociedad a fin de solucionar los problemas. Me siento orgulloso y destaco todo el mérito del grupo que estuvo trabajando . Un gran éxito y esperemos que se cumplan las etapas que faltan”..Luis Basterra, Ministro de Agricultura, Ganadería y Pesca de la Nación, se refirió al logro y señaló: “Entre el INTA y el CONICET nos muestran el potencial que tienen nuestros profesionales; lo que significa tener una política soberana en cuanto al desarrollo de conocimiento”. En este sentido, subrayó: “Este logro tiene calidad de anuncio internacional en términos de logro científico y nos pone a la vanguardia de lo que son las distintas alternativas para la lucha contra la COVID-19”.
Para Basterra, “este es el camino, el del compromiso y la interacción público privada para que este tipo de desarrollos contribuyan a resolver un problema tan grave como la COVID-19, pero, a la vez, formar capacidades para resolver estos problemas en el campo de la salud humana, animal y vegetal”.
 A su turno, Susana Mirassou –presidenta del INTA– señaló que es “un gran honor para el INTA estar a la altura de las circunstancias en un momento de pandemia, aportando conocimiento y desarrollos científicos, tales como la producción de nanoanticuerpos monoclonales”. En este sentido, indicó que se trata de “un momento realmente muy importante gracias a los equipos de trabajo de INTA asociados con CONICET que vienen transitando un largo camino desde 2005”.
A su turno, Susana Mirassou –presidenta del INTA– señaló que es “un gran honor para el INTA estar a la altura de las circunstancias en un momento de pandemia, aportando conocimiento y desarrollos científicos, tales como la producción de nanoanticuerpos monoclonales”. En este sentido, indicó que se trata de “un momento realmente muy importante gracias a los equipos de trabajo de INTA asociados con CONICET que vienen transitando un largo camino desde 2005”.“Es realmente un gran orgullo”, reconoció Mirassou, al tiempo que destacó el trabajo del equipo técnico de investigación y de campo que hizo posible este logro en tiempo récord. En esta línea, reconoció los aportes del sector privado para cooperar con equipamiento y con las llamas, que también contó con el financiamiento del Agencia Nacional de Investigación Científica.
“Es un paso importantísimo que da muestra de la sinergia que se genera cuando se trabaja de manera colaborativa fruto de la articulación publico privada, así se dinamiza, es la forma de trabajar: unidos y buscando soluciones, aportando a mejorar las soluciones para esta pandemia”, señaló.
Un logro internacional
“Los nanoanticuerpos monoclonales recombinantes VHH y los anticuerpos policlonales IgY representan dos estrategias para el tratamiento preventivo y terapéutico de pacientes afectados de COVID-19”, señaló Viviana Parreño, investigadora del CONICET en el Grupo Vinculado INCUINTA al Instituto de Virología e Innovaciones Tecnológicas (IVIT, CONICET-INTA), coordinadora científica de INCUINTA del INTA y responsable del proyecto junto con Itatí Ibañez, investigadora del CONICET en el Instituto de Química Física de los Materiales, Medio Ambiente y Energía (INQUIMAE).
Los ensayos que demostraron la actividad neutralizante de las moléculas fueron inicialmente realizados en el laboratorio por Itatí Ibañez con pseudo partículas virales y, paralelamente, confirmados con el virus salvaje en el Servicio de Virosis Respiratorias del Instituto Nacional de Enfermedades Infecciosas (INEI) de la ANLIS-Malbrán, por la investigadora Elsa Baumeister, y,en el Instituto Politécnico de Virginia -Estados Unidos-, por el científico Jonathan Auguste.
“Esperamos en tres meses contar con los ensayos preclínicos de los VHH e IgY neutralizantes en ensayos preclínicos en un modelo ratón para COVID-19”, reconoció Andrés Wigdorovitz, investigador del CONICET y director de INCUINTA y de Bioinnovo SA, la empresa de base tecnológica formada por INTA y Vetanco SA.
Las moléculas de llamas “representan una tecnología que permite administrar un producto farmacológicamente definido, un anticuerpo monoclonal recombinante, que podrá administrarse en forma de nebulización para prevenir o tratar la infección respiratoria, mientras que los anticuerpos IgY representan una terapia policlonal de aplicación tópica u oral”, destacó Parreño.
Los resultados obtenidos ubican a la Argentina “entre el selecto grupo de países que han desarrollado nanoanticuerpos: Estados Unidos, China, junto con Suecia y Bélgica, entre otras naciones de la Unión Europea”, afirmó y describió: “Este desarrollo científico posiciona al país como el primero en el hemisferio sur en dar cuenta de este logro”.
Este proyecto, elegido entre más de 900 propuestas en la convocatoria de la Agencia I+D+i en el marco de las acciones de la “Unidad Coronavirus” que integra junto con el Ministerio de Ciencia, Tecnología e Innovación y el CONICET, “demostró poder cumplir en tiempo record los objetivos que se propuso”, reconoció Itatí Ibañez, viróloga molecular, quien junto con Marina Bok y Florencia Pavan construyeron la biblioteca de genes VHH en tan sólo 10 días.
Una vez finalizadas las pruebas preclínicas y de seguridad en animales, se podrá comenzar con la fase de escalado y producción bajo buenas prácticas de manufactura, para su posterior prueba en ensayos clínicos con la aprobación de la autoridad regulatoria. De este modo, las dos estrategias se podrán sumar a las terapias de plasma e Igs humanas y de anticuerpos policlonales equinos que ya se encuentran en fase clínica.
La biblioteca de nanoanticuerpos
La inmunización de una llama en la unidad experimental del INTA y la posterior construcción de una biblioteca de nanoanticuerpos de llamas contra la COVID-19 fue la puerta de entrada para obtener nanoanticuerpos con la capacidad de inhibir la infección viral provocada por el coronavirus SARS-CoV-2.
En este recorrido de producir los nanoanticuerpos, los investigadores inmunizaron a Spike –nombre de la llama– con la proteína que forma la corona del SARS-CoV-2. Luego extrajeron una muestra de sangre y, de allí, los linfocitos circulantes. A partir de esas células se purificó el ARN –ácido ribonucleico– mensajero, que contiene información de los anticuerpos que elabora el camélido.
Este primer reservorio “elaborado en la Argentina contiene información genética sobre los anticuerpos que producen estos camélidos frente al SARS-CoV-2. Mediante un biopaneo de la biblioteca es posible seleccionar los anticuerpos que generan estos camélidos cuando son expuestos a la proteína del virus y que poseen la capacidad de neutralizar la infección viral”, señaló Marina Bok, investigadora de INCUINTA.
Este primer reservorio “elaborado en la Argentina contiene información genética sobre los anticuerpos que producen estos camélidos frente al SARS-CoV-2. Mediante un biopaneo de la biblioteca es posible seleccionar los anticuerpos que generan estos camélidos cuando son expuestos a la proteína del virus y que poseen la capacidad de neutralizar la infección viral”, señaló Marina Bok, investigadora de INCUINTA.Con la información codificada en los genes VHH se obtuvieron anticuerpos monoclonales que demostraron su capacidad para inhibir una infección viral utilizando tres ensayos de neutralización diferentes.
Los nanoanticuerpos y los anticuerpos IgY obtenidos podrán utilizarse como tratamientos preventivos y terapéuticos de COVID-19, aunque también son herramientas útiles para el desarrollo de métodos inmunodiagnósticos, entre otras aplicaciones.
Fuente. INTA
Viviana Parreño, coordinadora científica de la plataforma Incuinta, se refiere a este reservorio -único en Argentina- que permitirá obtener anticuerpos capaces de inhibir la infección viral provocada por el SARS-CoV-2.






